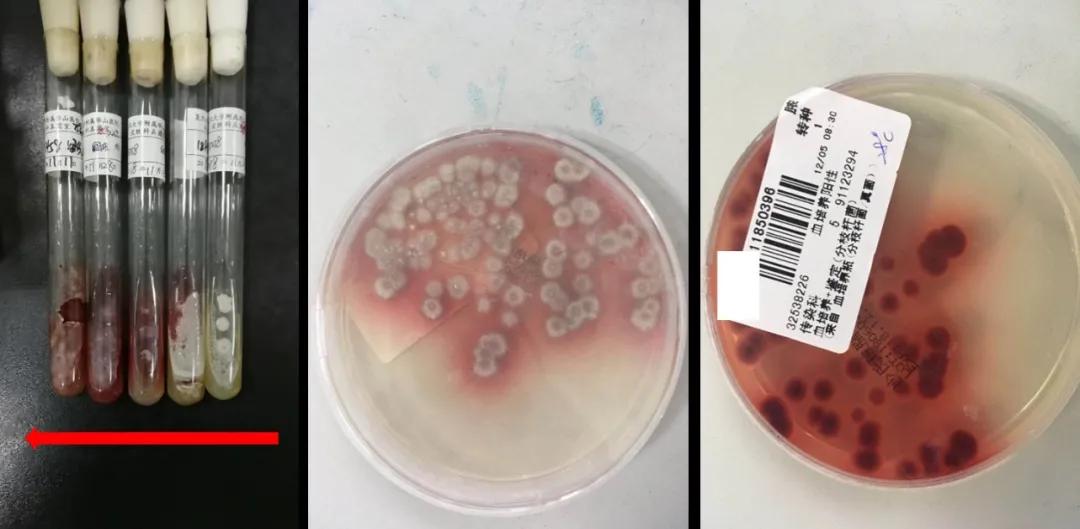
从感冒到癌症,从感冒到癌症只需九步

来源:华山感染
发热,淋巴结肿大,皮疹,关节痛,穿破颅骨的脓肿,让胸部糜烂的病变.....可能是因为比其他人多了一点抗体,让他们注定要与“怪病”长期缠斗......

38岁王女士坐在华山医院感染科的病房里,咳着嗽,发着烧。右边头顶鼓着一个软软的巨大包块,右侧的手脚还不太灵便。手臂和腿上布满米粒大小、亮晶晶的水疱。顺着医生在她脖子上和大腿根部上按来按去检查的地方,自己也能摸到肿块或者一粒粒像黄豆一样的东西,医生告诉她,那些是她肿大的淋巴结。

A:四肢部分消退的丘疱疹

头部CT:右顶骨骨质吸收破坏并周围软组织肿块形成
旁边的刘大姐一家正在欢天喜地收拾行李,准备明天出院,听说这里帮她摆平了长达半年断断续续的发烧,人脸色也明显红润了起来。刘大姐见王女士愁容满面,安慰她说,“大妹子,既然来了华山可就有点信心吧,我之前也是在外面治了好几个月没好,整个人都烧萎了,这不现在也被治好了吗。”
王女士回应了一个尴尬而不失礼貌的苦笑。她也想乐观一点,可是长达两年多的病痛折磨和辗转就医,已经让她逐渐绝望。得“怪病”两年多了,层出不穷的新发症状,病历本上收集了各种科室的印章,出院小结上的诊断越来越长。尽管已经身处传说中疑难感染的“最高法院”,王女士也不过是抱着“死马当活马医”的心态了。
痛苦的回忆:从“感冒”到“结核”到“肿瘤”
2年多前的一天,王女士有些咽痛、咳嗽,发了几天37.5-38.5℃的低烧。像往常一样她从家里翻了点头孢和感冒药吃了吃,没有好转,便去地段医院吊了点盐水,还推了针退热针。和往常不一样的是,这次的大招“吊盐水”和“打针”效果也只持续了两天,这次的”感冒“拖了十几天也没痊愈,还逐渐出现了胸闷气喘,并且持续的发烧让她吃不下,睡不好,浑身乏力。王女士去了大一点的医院,拍了个胸片,医生说没看到什么问题。医生先后给她换了很多不同的药,细心的王女士拿着一个塑料袋装上了压扁的药盒,每次复诊掏出来给医生看。一个多月的时间里,袋子里逐渐累积了左氧氟沙星、阿奇霉素、利巴韦林、头孢克洛、复方新诺明、元胡止痛片、黄连上清胶囊,盒子越来越多,症状却没有越来越好。
咳嗽发烧了1个多月时,医生建议王女士住院检查。住院期间,她拍了胸部CT,抽了套血,做了个皮肤鼓起了硬币大的结节的皮试(医生说这个检查叫结核菌素试验,而她皮肤鼓起的结节是阳性的表现),还做了支气管镜体验了一回濒临呛死的感觉。医生说,这次的胸部CT看到了她两肺有些炎症,左上肺还有个炎性结节,支气管镜看到了右边支气管管腔的狭窄,但是肺泡灌洗液和血都没培养出什么病菌。虽然没找到更强硬的证据,但考虑之前吃了各种抗菌药病情也没好转,“结核菌素试验”又是阳性,医生建议她试试抗结核治疗。于是王女士开始了“诊断性抗结核治疗”,惊喜的是5天过后她体温就正常了,咳嗽、胸闷也奇迹般消失了,复查的胸部CT也说炎症比前面好转。王女士松了口气,欢天喜地出院了,虽然没想通为什么会得“结核”,她也在家继续坚持吃神奇的“抗结核药”。
辅助检查:
胸部CT:两肺下叶慢性炎症或纤维化灶,左肺上叶炎性结节灶可能性大,两侧胸膜增厚、粘连并部分钙化;少量心包积液
纤维支气管镜:右中下叶支气管炎症表现,右中下叶管腔狭窄。
实验室检查:
血常规:白细胞、中性粒细胞百分比正常;
C反应蛋白:65mg/L,血沉120mm/h;
结核菌素皮肤试验(PPD):阳性;
肺泡灌洗液:未找到抗酸杆菌;真菌、细菌、抗酸杆菌培养阴性;
血培养:阴性。
治疗史:
1、阶段1:左氧氟沙星 0.5g qd ivgtt;疗效:无明显好转;
2、阶段2:异烟肼0.3g qd po+利福平0.45g qd po+吡嗪酰胺0.5g tid po+乙胺丁醇0.75g qd po;疗效:治疗5天后体温平,症状及影像学好转。
好景不长,没高兴几天王女士又开始咽痛、咳嗽了。这次没发烧,又吃着药,她再一次没放在心上。没想到咳了一个多月嗽,她又开始发烧了,并且脖子一侧开始肿痛,她自己摸到了一个肿块。王女士赶紧再次去了医院,拍了超声和CT,医生说脖子上是一串肿大的淋巴结,和她谈话说不能排除肿瘤。听到这个消息,王女士晚上偷偷哭了好几回,在她的概念里,“肿瘤”几乎是“死刑缓期”的同义词了。幸运的是,王女士淋巴结活检病理结果没看到肿瘤细胞,是“反应性增生”,医生告诉她说,通俗点讲就是炎症引起的。于是王女士又吊了几天抗生素,还用了中药热敷,让人宽慰的是,颈部的肿块好像小了不少。
辅助检查:
颈部CT:右侧颈部多发淋巴结肿大;
颈部淋巴结活检病理:淋巴结呈反应性增生;
实验室检查:
血常规:白细胞17.6×10^9/L,中性粒细胞百分比71.5%;
CRP 25.6mg/L,血沉 46mm/h;
治疗史:
1、阶段一:左氧氟沙星;疗效:无明显好转;
2、阶段二:头孢哌酮舒巴坦、倍他米松;疗效:治疗2天发热及疼痛好转;
3、阶段三:哌拉西林、阿米卡星;疗效:咽部疼痛消失,颈部肿块消退,但仍有发热
在皮肤科和风湿科辗转的日子
然而这 “怪病”显然没打算放过王女士。在颈部稍稍好转时,一夜之间忽然她的脸上又冒出了一堆亮晶晶的水疱,双腿也冒出很多硬硬的结节,按压时会很疼;两个膝关节也很痛。从这个时候起,她又开始在皮肤科和风湿科辗转。王女士先被考虑为“成人水痘”、“结节性血管炎”,期间皮疹不断变化,又出现了红斑、脓疱等,做了多次皮肤活检,又先后考虑“脓疱型银屑病”、“变态反应性结节红斑”、“Sweet综合征”、“带状疱疹”、“药物超敏综合征”。尽管皮肤科医生见招拆招,用了丙球、激素、各种抗过敏药物、免疫调节剂和各种对症药物,皮疹一次次的好转,但总是又有新的皮疹“前仆后继”地出现。原本光滑的皮肤已经面目全非,原本灵便的双腿也因为关节疼痛难以行走,还不到40岁,王女士就已经坐上了轮椅,被折腾得失去人形。
辅助检查:
(皮肤科就诊初期)胸部CT:左肺上叶下舌段、下叶各基底段及右肺中叶内侧段、下叶后基底段炎症,心包少量积液。
(皮肤科就诊初期)淋巴结活检:反应性增生。
(皮肤科就诊初期)活检组织培养(淋巴结、皮肤):真菌、细菌、分枝杆菌培养均阴性。
(皮肤科就诊初期)骨髓活检病理:未见特征性病理细胞。
(诊断Sweet综合征期间)右小腿结节活检病理:真皮皮下脂肪小叶间隔淋巴细胞、组织细胞及中性粒细胞结节状浸润,见多核细胞;
(诊断Sweet综合征期间)右小腿疱疹活检病理:真皮浅深层中性粒细胞及淋巴细胞灶状或结节状浸润,红细胞外溢明显,不排除血管炎;PAS、抗酸染色均阴性;
(诊断脓疱型银屑病期间)下肢红斑脓疱病理:经深切,表皮板层角化过度、灶性角化不全,局灶棘层轻度海绵水肿,真皮浅层血管周围少许淋巴细胞浸润,直接免疫荧光均为阴性。
(诊断脓疱型银屑病期间)皮肤活检:角化过度,灶状角化不全,表皮增厚,真皮乳头上顶,毛细血管迂曲扩张、充血,管周不等量炎性细胞浸润。
(诊断药物超敏综合征期间)四肢新发丘疹病理:表皮局部糜烂伴浆液性渗出,棘层灶性海绵水肿,其周围真皮浅层血管淋巴细胞浸润。
实验室检查:
血常规:白细胞10.4×10^9/L,中性粒细胞百分比70.5%;
炎症:CRP 172.6mg/L,血沉 103mm/h;
自身免疫:抗核抗体、抗中性粒细胞抗体、可提取性核抗原、抗心磷脂抗体、抗双链DNA、自身免疫性肝抗体谱均阴性;
治疗史
1、(诊断“成人水痘”期间):抗病毒及对症治疗;
2、(诊断“变态反应性结节红斑”期间):复方甘草酸苷,左西替利嗪,维生素C,头孢呋辛,雷公藤多苷;
3、(诊断“Sweet综合征”期间):复方甘草酸苷、维生素C、卡介菌、孟鲁斯特;
4、(诊断“Sweet综合征+带状疱疹”期间): 丙种球蛋白、甲泼尼龙、苯酚、氯雷他定、复方甘草酸苷、加巴喷丁;
5、(诊断“脓疱型银屑病、药物超敏综合征”期间):复方甘草酸苷片,阿维A胶囊,甲泼尼龙
短暂的曙光:非结核分枝杆菌?
王女士的磨难还远未到头。距离她最开始“感冒发烧”已经一年多了,现在,医生看着她长长地入院录,对她顽固的发热、多发肿大的淋巴结和不断变化的皮疹,还是没有什么头绪。这时候王女士的咳嗽和胸痛又加重了,再次回到感染科治疗。这次医生又取了她的淋巴结活检,而活检组织培养出一个病菌,医生说是“非结核分枝杆菌“(龟/脓肿分枝杆菌)。
这一会儿“结核”一会儿“非结核”,王女士并不明白发生了什么,只知道找到“罪魁祸首”算是好事。医生给她用了新的抗生素组合(头孢西丁+克拉霉素+莫西沙星),王女士的症状似乎又开始好转了,肿大的淋巴结也在缩小,并且在皮肤科和风湿科药物的辅助下,皮疹和关节痛也逐步好转了。吃了9个多月药,除了颈部几个顽固的淋巴结没有起色,其他地方的淋巴结都消下去了。医生挑了一颗顽固的淋巴结做了活检,说这次没有发现“非结核分枝杆菌”,结合王女士不断好转的症状,和9个月的疗程,医生给王女士停了药。但经历了几次希望后的失望,这一次,王女士不敢高兴得太早。
辅助检查:
淋巴结组织培养:非结核分枝杆菌,鉴定为龟/脓肿分枝杆菌;药敏:阿米卡星敏感,阿奇霉素敏感,氯法齐明敏感,莫西沙星耐药,克拉霉素耐药,多西环素耐药,乙胺丁醇耐药
(抗NTM治疗后)淋巴结穿刺活检病理:少许纤维组织急性及慢性炎症;分子病理-结核情况:TB-DNA(-),分枝杆菌基因检测(-),特殊染色结果:PAS(-),抗酸染色(-)
“肿瘤”和“脑卒中”:心理彻底崩溃
果然,“怪病”还是阴魂不散。停药短短几天王女士的淋巴结又开始渐渐变大了,皮肤上的小水疱也在全身如雨后春笋般冒了出来,头顶还鼓起了个大包。2年多的诊治经历已经让她觉得这“怪病”去了医院也没用,便和家人争执着拒绝去医院。但容不得她倔强两天,更诡异的事发生了。这天早上起来,王女士的右手、右腿都不听使唤了。难道瘫痪了?她慌乱地大呼家人,却只发出了含糊不清的声音。10多分钟后,在家人手忙脚乱要把她送医院去时,王女士好像又渐渐恢复了正常的行动和语言能力。正在和家人吵着不要去医院,同样的症状又发作了一次。于是王女士没有再坚持,和家人去医院。急诊的医生说她这可能是“短暂性脑缺血发作“,也就是传说中的“小中风”。拍的头颅CT让医生神色凝重,告诉王女士,头上的肿块已经把颅骨都穿破了;并且,CT不能排除脑梗死。于是王女士又住进了神经内科。住院期间她的症状又发作了两次,症状缓解后右侧的手脚也比不上左边灵便了。做了很多很多检查,反复听到的”CT“让王女士禁不住开始怀疑,是不是重复的检查。”医生,我们真的快没钱了,重复的检查能不做了么“。医生耐心解释,这些检查功能不一样。果然,每种检查都发现了不同的问题。MRI发现左侧有片脑梗死,CTA看到左边有根大的脑血管狭窄了,增强CT提示右边头顶的包块不能排除肿瘤,肺部CT发现支气管下段也有肿物。“我竟然脑梗了!”王女士难以置信。她的印象中,“中风”、“脑梗“是她爸妈那个年龄的人才该担心的问题。这次,王女士自己心里悄悄笃定这“怪病”真是肿瘤了,因为除了肿瘤,还有什么病能这么恶毒呢?
辅助检查:
头颅MR平扫+DWI:1. 左侧基底节区脑梗死可能大 2. 右顶部贯穿颅外肿块,肿瘤可能。
头颅CT增强:提示右顶骨骨质吸收破坏并周围软组织肿块形成,考虑炎性肉芽肿或肿瘤性病变;
头部CTA:左侧大脑中动脉水平段局部狭窄;
胸部CT:支气管下段肿物;
支气管肿物病理活检病理:肉芽肿性炎,镜下见炎性坏死及多核巨细胞反应,未见上皮样细胞,抗酸染色未见抗酸杆菌。
支气管肿物分枝杆菌菌种核酸:阴性。
王女士又做了一次痛苦的支气管镜。支气管镜从鼻孔进到肺部,她的气道始终想对抗这个入侵者,检查全程咳到抽搐。支气管肿物活检的病理报告上写着“肉芽肿”、“炎性坏死”、“多核巨细胞”等字眼,尽管不明白是什么东西,医生告诉她没发现肿瘤细胞时,王女士还是为自己高兴了一下,但马上又陷入了低落:不是肿瘤又怎样呢?到处都治不好,看病快花光家里积蓄,现在人也快瘫了,一身的毛病。
医生安慰王女士说,虽然这次的活检组织没找到病原,但从病理看这“怪病”是感染的可能性比较大,所以还有一线治愈的希望,让她去华山医院试试运气。
在华山
张文宏教授,邵凌云教授和郑建铭教授多次带着一群年轻医生过来查房。教授们一会儿问问王女士诊疗经过细节,一会儿考考年轻医生,一会儿在她身上叩诊触诊,一会儿抖出她的外院检查胶片对着阳光查看。看着年轻医生们既期待参与,又害怕被问倒的紧张样子,虽然王女士非常虚弱,也忍不住笑出了声。
一位年轻的医生汇报完这份冗长的病史。在补充询问完一些细节后,教授们开始总结和分析。
病史特点患者为中年女性,此前间断发热,伴咳嗽、皮疹和淋巴结肿大已两年余,早期先后予广谱抗细菌药物及抗病毒药物治疗,均疗效不佳。病程中,患者始终有CRP和血沉等炎症因子水平升高,胸部影像学结果提示肺部慢性炎症表现,有炎性结节。患者病程初期未找到明确的病原学依据。因患者发热多在午后, PPD阳性,故外院予诊断性抗结核治疗,治疗后患者体温恢复正常,复查胸部CT提示两肺下叶病灶较前吸收。然而,抗结核治疗一月后患者出现症状反复,并先后出现右侧颈部肿痛、面部疱疹、双下肢硬性压痛性结节等新的临床表现,浅表淋巴结B超提示全身多发淋巴结肿大。行淋巴活检,从真菌培养基上培养出非结核分枝杆菌,鉴定为龟/脓肿分枝杆菌,按NTM治疗有好转。NTM在治疗好转停药后症状再次反复,出现新发右顶部肿物、脑卒中症状,影像学检查提示右顶部软组织肿块和骨质破坏,肺部CT提示支气管下段肿物,病理活检提示肉芽肿性炎,镜下见炎性坏死及多核巨细胞反应。治疗方案多核巨细胞反应往往与分枝杆菌有关,我们先一边检查,一边继续予经验性抗NTM治疗,按既往为龟/脓肿分枝杆菌为快生长的分枝杆菌及既往的药敏结果,我们先予亚胺培南、阿米卡星联合阿奇霉素治疗。等待其他检查结果回报,再作进一步的调整。进一步检查考虑患者可能合并其他特殊病原体感染,抽取患者头皮包块脓液打入分枝杆菌血培养瓶送检(分枝杆菌血培养瓶既能培养出分枝杆菌,也能培养出真菌);请外科再做一次淋巴结活,送病理和培养。
虽然说着同一种语言,医生查房的讨论王女士却几乎一个字也没听懂。但看着教授们对她的病情梳理得非常有条理,做决策和下指示也非常果断,王女士和家里人多少感到安心了很多。
医生再次给王女士做了淋巴结活检、抽出她头顶包块的脓液(没错,它变得软软的竟然是因为化脓了),同时又开始了“吊盐水”和“打针”(亚胺培南+阿米卡星+阿奇霉素)。住了十几天院后,王女士终于不发烧了。
又过了两天,教授查房时告诉王女士,她头部的脓液和淋巴结组织都培养出了同一种真菌,叫“马尔尼菲篮状菌” 。真菌?王女士忍不住脑补自己头部长出来一朵蘑菇,或是一团毛绒绒的霉。
教授开始在床旁给学生讲课,王女士又进入了拼命想捕捉点信息却听得云里雾里的状态,什么“双相”、“葡萄酒”、“机会”、“免疫缺陷” 。医生给她加了一个叫“伊曲康唑”的抗真菌药,1周后,王女士开始有了精神,自己感觉身上的包块在减小,关节也不怎么疼了。
辅助检查:
淋巴结组织病理:(颈部)淋巴结化脓性炎性纤维化;
淋巴组织培养:马尔尼菲篮状菌,药敏:对两性霉素B、伊曲康唑、伏立康唑、氟胞嘧啶等药物均敏感;
头皮包块脓液培养:马尔尼菲篮状菌;
A:培养结果 B

B镜下所见
A.淋巴结活检组织及头颅包块脓液培养报阳,红色箭头所指的是培养时间的延长,菌株颜色的变化。马尔尼菲篮状菌在25度环境下病原体呈青霉相,培养48小时菌落大小为1~3mm,呈灰白色,72小时后菌落迅速增大变红,继续培养菌落颜色进一步加深呈葡萄酒样。B.马尔尼菲篮状菌镜下形态
多了这个抗体,让机会性感染找上门来
后面医生们给王女士讲解了,这个真菌也好,之前检查出的“非结核分枝杆菌”也好,在正常人中都比较少见,艾滋病的患者、用化疗药物的患者、器官移植后等等免疫力低下的患者才常见。王女士却两个菌都感染了,并且还播散到全身,是为什么呢?
教授们让王女士做了个“抗干扰素(IFN)-γ自身抗体检测”。她听说这个医院内还没开展,是华山感染的医生们在自己实验室里帮她检测掉的。结果显示王女士“抗IFN-γ自身抗体阳性”,教授给她讲解说,这个“干扰素γ”是人体内抵御胞内病原体的重要“将领”,她身体里的“自身抗体”,是她免疫系统把这个重要的“将领”当成敌人攻击了,并且阻挠了它率领“士兵”抵御一些细胞内病原体的活动。因此,正常人不太会感染的病菌,到王女士身上就成了四处播散的“怪病”。
真相水落石出,华山感染的医生再次调整抗感染方案后,王女士的病情也逐渐全面好转,她回到了家乡的医院继续治疗。
治疗经过:
1、阶段一:亚胺培南西司他丁1g q8h(11月15日-12月13日)+阿米卡星0.6g qd(11月15日-12月18日)+阿奇霉素0.5g qd(11月15日-);疗效:治疗11天后体温平; 2、阶段二:加用伊曲康唑250mg qd;疗效:治疗1周后患者一般状况及关节疼痛好转; 3、阶段三:(回当地医院)维持阿奇霉素+头孢西丁抗NTM治疗,伊曲康唑换回两性霉素B治疗,起始量为10mg,每天增加5mg,至40mg维持,治疗20天停药(累积量695mg);疗效:病灶持续好转,出院;4、阶段四:(出院当地医院随访)维持阿奇霉素+头孢西丁,出院3月后停用;口服伏立康唑200mg bid,半年后换用伊曲康唑。
未完待续
好转停药后,发热咳嗽又找上门来了一次,王女士又去了好几趟华山感染科复查,痰和血里都培养出了“萨斯喀彻温分枝杆菌”,王女士听医生讲解说,这又是一个“非结核分枝杆菌”。这次除了给王女士制订抗感染方案,华山感染的医生还尝试从根源上解决问题,用丙种球蛋白冲击治疗封闭王女士体内的抗IFN-γ自身抗体,然而效果并不尽人意。最后,调整抗感染方案控制住本次感染后,王女士出院继续维持口服药物治疗。
治疗经过: 1、阶段一(经验性治疗):亚胺培南/西司他丁1瓶q8h+阿奇霉素0.5g qd;疗效:体温逐渐降至正常,咳嗽明显改善; 2、阶段二(血及痰培养NTM报阳):加用利奈唑胺600mg qd强化抗NTM;疗效:病情持续好转; 3、阶段三:伏立康唑200mg bid抗真菌,亚胺培南/西司他丁1g q8h+阿奇霉素500mg qd+利奈唑胺600mg qd抗NTM;疗效:维持治疗2月,病灶持续好转,换口服药出院;4、阶段四:伏立康唑200mg q12h + 阿奇霉素0.5g qd+利奈唑胺0.6g qd口服维持治疗;疗效:病情控制稳定;5、尝试的封闭抗体治疗:人免疫球蛋白20g 冲击治疗×3天;疗效:用药前后IFN-γ抗体滴度并无明显降低。
后来,王女士一直口服伏立康唑、阿奇霉素和利奈唑胺,头顶和身上的肿块全部消退了,定期回华山复查,多次复查头颅增强CT,头颅MR和淋巴结超声都未再见异常。前一次复查时,让华山的教授们都惊喜的是她的抗IFN-γ自身抗体滴度显著下降,几近转阴。
不过,教授们叮嘱王女士,尽管抗IFN-γ自身抗体与她的反复感染密切相关,但未必就是唯一的因果关系,有研究显示,抗体滴度下降的部分患者仍会罹患反复或严重的感染。
王女士点点头,好不容易回归了正常生活,以后一定不会掉以轻心,会把“坚持用药,密切随访”放在心上。
注:部分图片来源于网络及微信朋友圈,尊敬的图片作者,您好,医师报全媒体平台已经按报社标准为你准备了稿费,请您与我们联系。